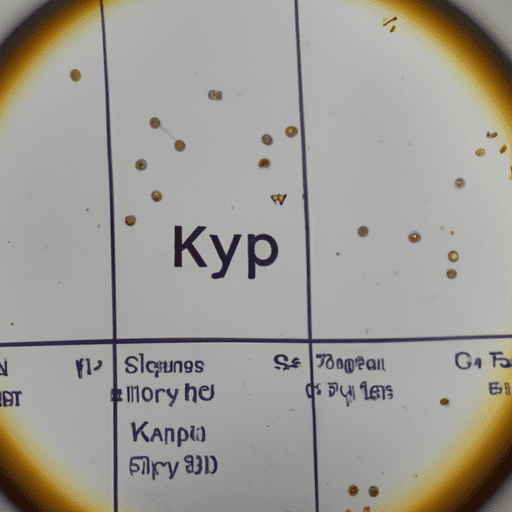

The KVPY (Kishore Vaigyanik Protsahan Yojana) is a scholarship program aimed at encouraging talented students to pursue a career in science and research. Every year, thousands of students from all over India participate in the KVPY exam hoping to secure a scholarship and recognition for their hard work and dedication. The KVPY result is eagerly awaited by students, parents, and educators alike, as it represents the best and the brightest of the country’s young minds.
KVPY Result: Celebrating the Best and the Brightest!
The KVPY is a prestigious scholarship program that recognizes and rewards exceptional students in the field of science and research. The KVPY result is a celebration of the best and the brightest of India’s young minds, who have demonstrated their talent, creativity, and innovation in the field of science. The KVPY scholarship not only provides financial support but also gives students an opportunity to interact with eminent scientists, attend workshops and conferences, and participate in research projects.
The KVPY result is a source of pride and joy for students, parents, and educators. It is a testament to the hard work, dedication, and passion that these young minds have put into their studies. The KVPY scholarship is a stepping stone for many young scientists who dream of making a difference in the world of science and research. The KVPY result is not just a number, but a symbol of hope and inspiration for the next generation of scientists and innovators.
The KVPY Result is Out! Here’s What You Need to Know.
The KVPY result is finally out, and it’s time to celebrate the achievements of the best and the brightest of India’s young minds. The KVPY scholarship is awarded to students who have excelled in the field of science and research and have demonstrated a strong commitment to pursuing a career in this field. The KVPY result is based on the performance of the students in the exam, followed by an interview conducted by a panel of experts.
The KVPY result is available online, and students can check their results by visiting the official website. Successful candidates will be notified by email and will also receive a letter from the KVPY office. The KVPY scholarship provides financial support to students for a period of five years, starting from the first year of their undergraduate course in science. This scholarship is a great opportunity for students who are passionate about science and research and want to make a difference in the world.
The KVPY result is a celebration of the best and the brightest of India’s young minds. It is a testament to the hard work, dedication, and passion that these students have put into their studies. The KVPY scholarship is not just a financial reward, but an opportunity for students to pursue their dreams and make a difference in the world. We congratulate all the successful candidates and wish them all the best for their future endeavors. Keep shining bright!
The long wait is finally over. The Kishore Vaigyanik Protsahan Yojana (KVPY) results are finally released and the nation’s finest young minds are now reaping the fruits of their hard work. KVPY is an aptitude test for school students, conducted by IISc Bangalore, for aspiring scientists.
The exam includes a written test assessment, followed by a personal interview. It is conducted to provide assistance to bright students enrolled in college and school, who are interested in pursuing professional courses in science, who show promise of becoming successful scientists and engineers.
This year’s exam had a total of 1.95 lakh applicants, which makes it one of the most popular competitive examinations in the country. After a process of rigorous selection, around 7,650 students were selected for further round of evaluation.
The three categories of KVPY results, SA, SX and SB were announced this week. Out of these, the SA (Stream SA) category consists of students studying in Classes 11 and 12, who were selected for the Award Fellowship program. In the SX (Stream SX) category, students who have enrolled in Basic Science courses like B.Sc. / B.S. / B.Math. / B.Stat. are included, while in the SB (Stream SB) category, candidates who have enrolled in Integrated M.Sc./M.S. /MSc Applied Sciences course have been selected.
The list of successful students includes candidates from across the country and the total number of successful candidates are 7600. A total of 1000 SA stream students, 2,600 SB candidates and 4,000 SX applicants have been selected.
The winners will be rewarded with a hefty amount of scholarship every year till their graduation. All the candidates must remember to keep checking in with the official KVPY results website, regularly, in order to avail the scholarship benefit.
Candidates who have been fortunate enough to clear the exam should make the most of this opportunity and pursue their dreams of becoming scientists and engineers. Congratulations to all the young and deserving KVY winners!